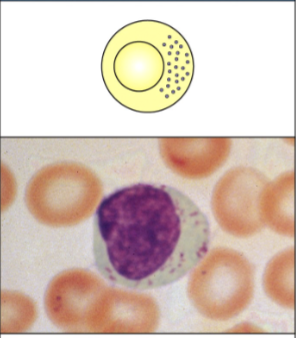
<p>____: releases lytic granules that kill some virus-infected cells </p>

micro 405: immunology
1/380
There's no tags or description
Looks like no tags are added yet.
Name | Mastery | Learn | Test | Matching | Spaced | Call with Kai |
|---|
No analytics yet
Send a link to your students to track their progress
381 Terms
what is immunology?
the study of physiological mechanisms that humans and other animals use to defend bodies from invasion by other organisms
a historical perspective of immunology and vaccinations
Dr. Edward Jenner observed that dairy farmers were immune to smallpox
smallpox disease is highly contagious and often deadly, whereas _____ is a mild form of smallpox
inoculation with it was done to prevent humans from contracting smallpox
cowpox
what are the main components of immunology?
innate and adaptive immunity

overview of immunologic networks
pathogens enter the body through mucosal surfaces or skin
the pathogen is detected by resident phagocytic cells (yellow), triggering ______
innate immunity

overview of immunologic networks
free pathogen and some phagocytic cells that have engulfed the pathogen flow or migrate through lymphatic vessels toward ______ (e.g. lymph nodes)
secondary lymphoid structures

overview of immunologic networks
they intersect with lymphocytes entering from the blood
______ is initiated in secondary lymphoid tissues, where T helper cells (blue), T cytotoxic cells (red), and B cells (green), which result in proliferation and differentiation
adaptive immunity

overview of immunologic networks
T and B cells migrate out of the lymph node
as they identify areas of infection, they migrate toward the infection, where they can help and destroy any remaining pathogen (the ____ phase)
_____ are generated
effector, memory cells
how do we generate immune cells?
______
the process by which hematopoietic stem cells (HSCs) differentiate into mature blood cells
stems cells are defined by two capacities:
the ability to regenerate or “self-renew”
the ability to differentiate into diverse cell types
hematopoiesis
generation of immune cells (hematopoiesis)
______ generate lymphocytes
common lymphoid progenitor
generation of immune cells (hematopoiesis)
_______ generate myeloid cells
common myeloid progenitor

generation of immune cells (hematopoiesis)
myeloid cells are _____
innate

generation of immune cells (hematopoiesis)
lympoid cells are _____
adaptive
the myeloid lineage: innate cells
what are the innate cells?
granulocytes and phagocytes

the myeloid lineage: innate cells
_______
include neutrophils, eosinophils, basophils, and mast cells
first responders to multiple extracellular pathogens, including bacteria/parasitic worms
when activated, they release contents of _____, which directly and indirectly impair pathogen activity
also release ______ that influence adaptive immune response and are potent contributors to allergic respones
granulocytes, granules, cytokines

the myeloid lineage: innate cells
_______
include macrophages and dendritic cells
when activated by an _____, they can activate T lymphocytes
dendritic cells are the most potent antigen-presenting cell for naive T cells
phagocytes, antigen

the myeloid lineage: innate cells
what are the granulocytes?
neutrophils, eosinophils, basophils, and mast cells
the myeloid lineage: innate cells
what are the phagocytes?
macrophages and dendritic cells

the myeloid lineage: innate cells
granulocytes
_____: phagocytosis and activation of bactericidal mechanisms
neutrophil

the myeloid lineage: innate cells
granulocytes
______: killing of antibody-coated parasites
eosinophil

the myeloid lineage: innate cells
granulocytes
______: promotion of allergic responses and augmentation of anti-parasitic immunity
basophil

the myeloid lineage: innate cells
granulocytes
______: release of granules containing histamine and active agents
mast cell

the myeloid lineage: innate cells
phagocytes
_____: phagocytosis and activation of bactericidal mechanisms (antigen presentation)
macrophages

the myeloid lineage: innate cells
phagocytes
_____: antigen uptake in peripheral sites (antigen presentation)
most potent antigen-presenting cells for naive T cells
dendritic cells
the myeloid lineage: innate cells
what do granulocytes release to trigger allergic responses?
cytokines
lymphocytes are mediators of adaptive immunity
lymphocytes include B cells and T cells which are the principal players in the adaptive immune response and the source of _____
B and T cells express unique ______ on their surfaces: the B-cell receptor (BCR) and the T-cell receptor (TCR)
activated B cells can present antigens to T cells
B cells ultimately differentiate into antibody producing cells called _______
T lymphocytes include CD4+ helper T cells and CD8+ cytotoxic T cells
natural killer (NK) cells can kill some infected and tumor cells
immune memory, antigen receptors, plasma cells
lymphocytes are mediators of adaptive immunity
what are the lymphocytes?
B and T cells
lymphocytes are mediators of adaptive immunity
what are B cells that have differentiated into antibody-producing cells called?
plasma cells
lymphocytes are mediators of adaptive immunity
what are the T lymphocytes?
CD4+ helper T cells and CD8+ cytotoxic T cells
lymphocytes are mediators of adaptive immunity
what T lymphocyte recognizes peptides bound to MHC class II?
CD4+ helper T cell
lymphocytes are mediators of adaptive immunity
what T lymphocyte recognizes peptides bound to MHC class I?
CD8+ cytotoxic cell

types of antigen receptors
B cell receptors (BCR) are _____ and can be either cell-associated or soluble (antibodies)
they have 2 identical antigen-binding sites, and each B cell is specific for a single antigen
bivalent
types of antigen receptors
B cell receptors (BCR)
antibody: _____
soluble
types of antigen receptors
B cell receptors (BCR)
BCR: ______
membrane-bound
types of antigen receptors
T cell receptor (TCR) are surface molecules. they have a ____ antigen binding site that is specific for the antigen that is presented in association with an MHC molecule
each T cell clone is specific for a single antigen/MHC combination
single
types of antigen receptors
B cell and T cell each have one _____ specificity
antigen
B cells
B cells (lymphocytes) develop in the bone marrow
produce _____: proteins that bind to antigens
each cell expresses a unique B cell receptor
antibodies
T cells
development depends on the ____
two kinds of T cells: helper cell with CD4 on surface and cytotoxic cell with CD8 on surface
each cell expresses a unique T cell receptor
thymus
natural killer (NK) cells
lymphocytes but participates in innate immunity
provide defense against viruses, bacteria, and tumor cells
are able to recognize and lyse target cells lacking _____
MHC class I
____: releases lytic granules that kill some virus-infected cells
natural killer (NK) cells

dendritic cells
both myeloid and lymphoid
activate T cells as antigen presenting cells (APC)
____ innate immunity to adaptive immunity
bridge
three phases of immune responses upon infection
innate immunity
_____: 0-4 hours
infection → recognition by preformed,
nonspecific and broadly specific effectors → removal of infectious agent
immediate
three phases of immune responses upon infection
_______
early: (4-96 hours)
infection → recruitment of effector cells → recognition of PAMPs. activation of effector cells and inflammation → removal of infectious agent
early induced innate response
three phases of immune responses upon infection
_______
late: >96 hours
infection → transport of antigen to lymphoid organs → recognition by naive B and T cels → clonal expansion and differentiation to effector cells → removal of infectious agent
adaptive immune response
two arms of immunity
innate immunity
immediate
constitutive
includes myeloid cells and NK cells, complement, and other factors
depend on the ability to distinguish molecules expressed by microbes
protection by ______ or destruction of non-self structures
neutralization
two arms of immunity
adaptive immunity
delayed
inducible
includes T and B cells with specific receptors
depends on the _____ with specificity of the receptors on B and T cells
generates memory cells and responses
diversity
the immune system protects against four classes of pathogens
what are they?
viruses, intracellular bacteria, extracellular bacteria, and parasitic worms

two different types of pathogen recognition by immune cells
_______
innate cells (granulocytes, macrophages)
innate immunity
pattern-dependent recognition
two different types of pathogen recognition by immune cells
_______
adaptive cells (B and T cells)
adaptive immunity
antigen-specific recognition

an example of pattern-dependent recognition: neutrophils and macrophages
_____ express pattern recognition receptors for an initial discrimination between self and non self
sensor cells

an example of pattern-dependent recognition: phagocytes
______ agents produced by phagocytes after taking up microorganisms
bactericidal
what are the key features of the adaptive immune response?
specificity, diversity, self-tolerance, and memory

four characteristics of adaptive immune responses
______ of recognition by cells and molecules
the cells and molecules in the immune system recognize the particular antigen that they are selected for one million-fold better than (most) all other antigens
specificity
four characteristics of adaptive immune responses
_____ of recognition
immune system can recognize ten million or more different antigens
diversity

four characteristics of adaptive immune responses
______
depending on how an antigen is encountered, the immune system can become nonresponsive to that antigen.
maammals and birds are tolerant to self-antigens
tolerance
four characteristics of adaptive immune responses
_____ or secondary responses
the immune response upon a second encounter with an antigen is stronger, faster, and qualitatively different than the first encounter with an antigen
memory

lymphoid organs
______ lymphoid organs is where immune cells develop
primary

lymphoid organs
_____ lymphoid organs are where immune response is initiated
lymph nodes, spleen
secondary
clonal selection
clonal selection is the process by which individual lymphocytes are either activated to produce a clone (positive selection) or deleted to prevent a clone from developing (negative selection)
each lymphocyte expresses a single antigen specificity
recognition of that antigen results in lymphocyte activation
activation results in the _______ of that lymphocyte and the formation of a _____, all of which express the same antigen specificity
______ lymphocytes are deleted during development and are not present in the circulation
proliferation, clone, self-reactive
clonal selection
what is positive selection?
when an individual lymphocyte is activated to produce a clone
clonal selection
what is negative selection?
when an individual lymphocyte is deleted to prevent a clone from developing
a _____ in the gut epithelial, secretes mucus to protect epithelial cells from microorganism invasion
goblet cell
key elements of innate immunity
the first line of defense
physical and chemical barriers that prevent infection, provided by the _____ layers of the skin, _____ tissues (ex. gastro, respiratory, and urogenital tracts), and _____ tissues (ex. salivary and mammal glands)
epithelial, mucosal, glandular
what is included in the mucosal immunology?
skin, mouth, airway lung, large intestine, and small intestine

key elements of innate immunity
the second line of defense
recognizes pathogen components and triggers a variety of cellular responses
pathogen recognition by these receptors activates some cells to ______ and degrade the pathogen
phagocytose
key elements of innate immunity
activation of innate immune responses kills pathogens and produces _______ and _______ that recruit cells, molecules, and fluid to the site of infection, leading to swelling and other symptoms collectively known as ________
cytokines, chemokines, inflammation
two major components of innate immunity
____ mediators
anti-microbial peptides
cytokines and chemokines
complement
____ mediators
cell types: granulocytes, phagocytes, and NK cells
receptors in innate immunity
pathogen-associated molecular patterns (PAMPs) on microbes are recognized by pattern recognition receptors (PRRs) on host cells
PAMP-PRR interaction induces inflammation
soluble, cellular
two major components of innate immunity
what are the soluble mediators of innate immunity?
antimicrobial peptides, cytokines/chemokines, and complements
two major components of innate immunity
what are the cellular mediators of innate immunity?
granulocytes, phagocytes, NK cells, PAMPs, and PRRs
two major components of innate immunity
cellular mediators
______ interaction induces inflammation
PAMP-PRR
two major components of innate immunity
pathogen-associated molecular patterns (PAMPs) on microbes are ______ by pattern recognition receptors (PRRs) on host cells
recognized
soluble mediators
antimicrobial peptides
_______ produced by phagocytes after taking up microorganisms
macrophage products: cathelicidin, macrophage elastase-derived peptide
neutrophil products: lactoferricin, azurocidin, etc.
bactericidal agents


soluble mediators
in response to invasion or threat, immune cells ______ with each other using chemical messengers such as cytokines and chemokines
communicate
soluble mediators
cytokines
____ that stimulate or inhibit the differentiation, proliferation, or function of cells
produced by immune and non-immune cells
one cell may produce many cytokines
one cytokines may be produced my many different cells
proteins
soluble mediators
cytokines
______: cytokines that act on leukocytes
IL-#, up to IL-1 up to IL-33
______: cytokines that prevent (“interfere with”) viral infection
IFNs
interleukins, interferons
soluble mediators
cytokines
what are cytokines that act on leukocytes?
interleukins
soluble mediators
cytokines
what are cytokines that prevent (“interfere with”) viral infection?
interferons
soluble mediators
_____: a family of structurally related cytokines that selectively induced chemotaxis and activation of leukocytes
chemokines

soluble mediators - introduction of the complement system
activation by _____
by 3 different initiators that bind to pathogens:
classical pathway, lectin pathway, and alternative pathway
_____
a cascade of proteolysis follows, generating the central proteins of the complement cascade, the C3 and C5 convertases
three outcomes
opsonization
inflammation
cell lysis by the membrane attack complex (MAC)
microbes, proteolytic cascade

soluble mediators - introduction of the complement system
proteolytic cascade
a cascade of proteolysis follows, generating the central proteins of the complement cascade, the _____
C3 and C5 convertases
soluble mediators - introduction of the complement system
what are the three outcomes of the complement system?
opsonization, inflammation, and cell lysis by MAC
soluble mediators - introduction of the complement system
______: coating pathogen with antibodies and/or complement proteins → readily taken up by phagocytes
opsonization

cellular mediators
sensor cells express ________ for an initial discrimination between self and non-self
ex. neutrophils and macrophages
macrophages also activate adaptive immunity, so a little different than neutrophils
pattern recognition receptors (PRRs)
characteristics of natural killer (NK) cells
lymphocytes but participate in innate immunity
provide defense against viruses, bacteria, and tumor cells
recognize and lyse target cells lacking ______
NK cell-mediated activation involves the secretion of cytokines, in particular, INF-𝛾 and direct ____-dependent cytolysis of target cells
NK cell activity is controlled by an array of activating and inhibitory receptors
MHC class I, perforin
NK cell killing: a question of balance
NK cell inhibition
MHC class I on normal cell is recognized by inhibitory receptors that inhibit signals from activating receptors → NK cell does not lyse normal cell
NK cell activation
absent MHC class I cannot stimulate a negative response → activated NK releases granule contents, inducing _____
virus-infected cells and tumor cells _____ MHC
apoptosis, downregulate

summary of NK cell killing
the major histocompatibility (MHC) is expressed by healthy cells as an indication of “self”
NK cells can recognize MHC markers on the surface of healthy cells, and these MHC markers serve as an _____ signal preventing NK cells from activation
to kill, NK cells need a second signal - called _______ - confirming that the target is altered meaning transformed or infected
NK cells synthesize (perforin and granzymes) stores in lytic granules.
Cytotoxins are secreted upon receptor engagement
inhibitory, activating signal
how do innate immune cells sense pathogens?
_______
pathogen-associated microbial patterns (PAMP)
the molecules expressed in microbes and recognized by innate immune cells
ex. cell wall carbohydrates, flagellin, non-methylated CpG
pathogens
how do innate immune cells sense pathogens?
_______
pathogen recognition receptors (PRR)
the receptors expressed on host cells and recognize PAMPs and other microbial-associated molecules
ex. TLR, NLR, RLR
immune cells
pathogen-associated molecular patterns (PAMPs)
PAMPs are signature molecules expressed only in _____ such as bacteria, viruses, fungi, but not in human cells
PAMP are repeating ______ common to many microbes within the same group
PAMP can be found on the surface of the pathogen (surface pattern) or inside the pathogen (intracellular pattern)
microbes, structural motifs
pathogen-associated molecular patterns (PAMPs)
where can PAMPs be found on microbes?
surface of pathogen (surface pattern) and inside the pathogen (intracellular pattern)
examples of PAMPs
bacteria
surface: cell wall components and _____
intracellular: unmethylated _____
flagella, CpG DNA
examples of PAMPs
viruses
surface: cell surface proteins
intracellular: _____ and _____
ds-RNA, ss-RNA
examples of PAMPs
fungi
surface: ______
intracellular: none
cell wall
pattern recognition receptors (PRRs) - sensors
pattern recognition receptors (PRRs) are proteins capable of recognizing PAMPs
they emerged phylogenetically before the appearance of adaptive immunity and, therefore, are considered to be part of the innate immune system
PRRs are associated with subcellular compartments, such as the cellular and ______ membranes, the _____, and extracellularly
there are four major subfamilies of PRRs
toll-like receptors (TLR)
nucleotide-binding oligomerization domain NOD leucin-rich repeats containing receptors (NLR)
retinoic acid-inducible gene 1 RIG-1-like receptors (RLR)
cytosolic DNA sensor cGAS
endosomal, cytosol
pattern recognition receptors (PRRs) - sensors
what are four major subfamilies of PRRs?
toll-like receptors (TLR), NOD-like receptors (NLRs), RIG-1-like receptor (RLR), and cyclic GMP-AMP synthase (cGAS)
toll-like receptors
______
are found either on the surface cell or intracellularly
recognize different things bc different locations
TLR-1 → TLR 9

TLR signaling pathway in innate immune cells
______ signals send cascades to activate pro-inflammatory cytokines
IL-6, IL-1β, TNF-⍺
surface
TLR signaling pathway in innate immune cells
what are the pro-inflammatory cytokines?
IL-6, IL-1β, TNF-⍺

TLR signaling pathway in innate immune cells
_____ activates type I IFNs induces anti-viral infection on targets
IFN-⍺ and IFN-β
intracellular
TLR signaling pathway in innate immune cells
what are the type I interferons?
IFN-⍺ and IFN-β

nucleic acid-binding TLRs can trigger interferon (IFN) production
virus-infected host cells → produce IFN-⍺ and IFN-β → induce innate immune responses and activate ____ cells to kill virus-infected cells → recruit lymphocytes and induce _______
NK, adaptive immunity